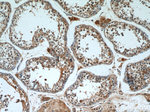
SKAP55 Antibody in Immunohistochemistry (Paraffin) (IHC (P))

Search
Proteintech
SKAP55 Polyclonal Antibody
{{$productOrderCtrl.translations['antibody.pdp.commerceCard.promotion.promotions']}}
{{$productOrderCtrl.translations['antibody.pdp.commerceCard.promotion.viewpromo']}}
{{$productOrderCtrl.translations['antibody.pdp.commerceCard.promotion.promocode']}}: {{promo.promoCode}} {{promo.promoTitle}} {{promo.promoDescription}}. {{$productOrderCtrl.translations['antibody.pdp.commerceCard.promotion.learnmore']}}
产品信息
19247-1-AP
种属反应
宿主/亚型
分类
类型
抗原
偶联物
形式
浓度
规格
纯化类型
保存液
内含物
保存条件
运输条件
产品详细信息
Immunogen sequence: MQAAALPEE IRWLLEDAEE FLAEGLRNEN LSAVARDHRD HILRGFQQIK ARYYWDFQPQ GGDIGQDSSD DNHSGTLGLS LTSDAPFLSD YQDEGMEDIV KGAQELDNVI KQGYLEKKSK DHSFFGSEWQ KRWCVVSRGL FYYYANEKSK QPKGTFLIKG YGVRMAPHLR RDSKKESCFE LTSQDRRSYE FTATSPAEAR DWVDQISFLL KDLSSLTIPY EEDEEEEEKE ETYDDIDGFD SPSCGSQCRP TILPGSVGIK EPTEEKEEED IYEVLPDEEH DLEEDESGTR RKGDYASYYQ GLWDCHGDQP DELSFQRGDL IRILSKEYNM YGWWVGELNS LVGIVPKEYL TTAFEVEER (1-358 aa encoded by BC047870 )
靶标信息
This gene encodes a T cell adaptor protein, a class of intracellular molecules with modular domains capable of recruiting additional proteins but that exhibit no intrinsic enzymatic activity. The encoded protein contains a unique N-terminal region followed by a PH domain and C-terminal SH3 domain. Along with the adhesion and degranulation-promoting adaptor protein, the encoded protein plays a critical role in inside-out signaling by coupling T-cell antigen receptor stimulation to the activation of integrins.
仅用于科研。不用于诊断过程。未经明确授权不得转售。
篇参考文献 (0)
生物信息学
蛋白别名: epididymis secretory sperm binding protein Li 81p; ortholog of human src family associated phosphoprotein 1 SCAP1; pp55; SKAP-55; SKAP55; SKAP55 adapter protein; SKAP55 adaptor protein; src family associated phosphoprotein 1; Src family-associated phosphoprotein 1; Src kinase-associated phosphoprotein 1; Src kinase-associated phosphoprotein of 55 kDa; unnamed protein product
基因别名: 1700091G21Rik; HEL-S-81p; SCAP1; Skap-55; SKAP1; SKAP55
UniProt ID: (Human) Q86WV1, (Mouse) Q3UUV5, (Rat) Q4V7G1
Entrez Gene ID: (Human) 8631, (Mouse) 78473, (Rat) 286975